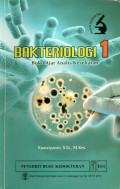
cover

Bakteriologi 2: buku ajar analis kesehatan
This Health Analyst textbook is intended for health students, especially Health Analysts or Medical Laboratory Technology in which it discusses bacteriological characteristics, both in general and …
- Edisi
- Cetakan pertama
- ISBN/ISSN
- 978-979-044-713-4
- Deskripsi Fisik
- 130 halaman ; 23 cm.
- Judul Seri
- -
- No. Panggil
- 616.92 KUS b

Buku ajar virologi untuk analis kesehatan
Handbook of Virology for Health Analysts is the first book compiled by health analyst educators and the first available for health analyst students. The contents adjust the teaching and learning ne…
- Edisi
- Cetakan pertama
- ISBN/ISSN
- 978-979-044-669-4
- Deskripsi Fisik
- xii, 188 halaman : ilustrasi ; 21 cm.
- Judul Seri
- -
- No. Panggil
- 616.92 KUS b

Bakteriologi 1 : Buku Ajar Analis Kesehatan
- Edisi
- -
- ISBN/ISSN
- 978-979-044-608-3
- Deskripsi Fisik
- xi, 146 halaman ; 24 cm.
- Judul Seri
- -
- No. Panggil
- 616.920 1 KUS b
- Edisi
- -
- ISBN/ISSN
- 978-979-044-608-3
- Deskripsi Fisik
- xi, 146 halaman ; 24 cm.
- Judul Seri
- -
- No. Panggil
- 616.920 1 KUS b
Hasil Pencarian
Ditemukan 3 dari pencarian Anda melalui kata kunci: Pengarang : Kuswiyanto
Permintaan membutuhkan 0,0008 detik untuk selesai

Karya Umum
Karya Umum  Filsafat
Filsafat  Agama
Agama  Ilmu-ilmu Sosial
Ilmu-ilmu Sosial  Bahasa
Bahasa  Ilmu-ilmu Murni
Ilmu-ilmu Murni  Ilmu-ilmu Terapan
Ilmu-ilmu Terapan  Kesenian, Hiburan, dan Olahraga
Kesenian, Hiburan, dan Olahraga  Kesusastraan
Kesusastraan  Geografi dan Sejarah
Geografi dan Sejarah